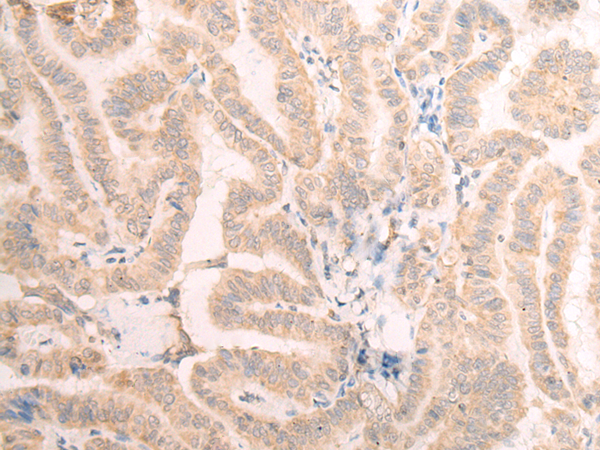

|
Background: |
Interacts with MUS81 to form a DNA structure-specific endonuclease which cleaves substrates such as 3'-flap structures. |
|
Applications: |
ELISA, WB, IHC |
|
Name of antibody: |
EME2 |
|
Immunogen: |
Synthetic peptide of human EME2 |
|
Full name: |
essential meiotic structure-specific endonuclease subunit 2 |
|
Synonyms: |
SLX2B; gs125 |
|
SwissProt: |
A4GXA9 |
|
ELISA Recommended dilution: |
5000-10000 |
|
IHC positive control: |
Human thyroid cancer and Human ovarian cancer |
|
IHC Recommend dilution: |
30-150 |
|
WB Predicted band size: |
41 kDa |
|
WB Positive control: |
231 cell lysate |
|
WB Recommended dilution: |
200-1000 |

購物車
幫助
021-54845833/15800441009
